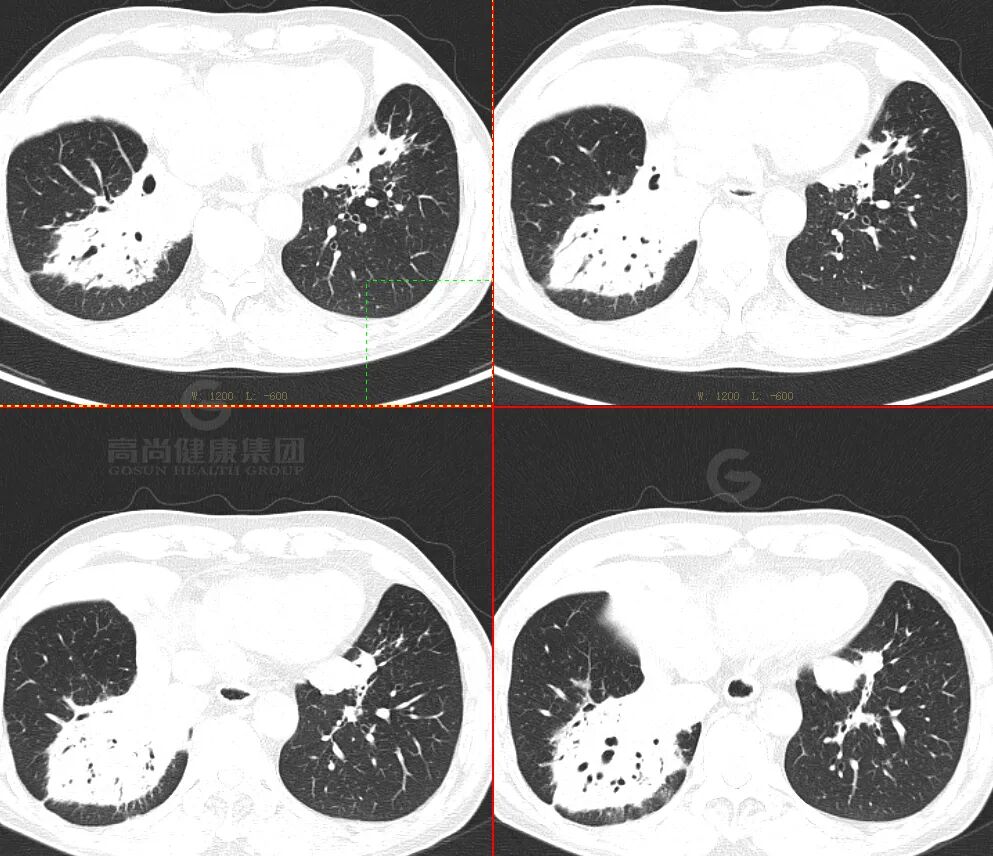
【高尚病例】肺曲霉菌病——「塔宾曲霉」

高尚医学影像诊断中心病例
病例-病史摘要
女性 69 岁,发现左肺占位 3 天。
无明显诱因出现咳嗽一周, 偶感胸前区疼痛,持续数秒可缓解,无发热。入院后行冠状动脉 CTA 检查发现左肺肿块,为进一步评估病变性质行全身 PET/CT 检查。
高血压 高危组;2 型糖尿病。
实验室检查结果
血常规+超敏 C 反应蛋白组合:
C 反应蛋白 (超敏)CRP 24.75 mg/L↑,白细胞 WBC 10.36x109/L↑,中性粒细胞 NEUT 7.04x 109/L↑,单核细胞 0.56x109/L↑,平均红细胞血红蛋白浓度 MCHC 316.0 g/L↓,血小板 PLT 340x 109/L↑,血小板压积 PCT 0.337%↑。
肿瘤标志物:CA125 ↑ 68.2,NSE ↑ 18.9,CEA、SCC、CFRA21-1 正常。
· 中心医学影像检查资料 ·
PET/CT 图像










CT 图像



CT 增强图像




病例特点
· 老年女性,糖尿病患者,病程短
· 影像表现重,临床症状相对轻
· 双肺多发结节、肿块,周围晕征
· 以胸膜下分布为主
· 强化较明显,未见空洞、钙化,坏死不明显
· FDG 代谢增高,SUVmax 为 18.3
病理结果
(左肺下叶) 穿刺组织,其内可见纤维组织显著增生,其间散在少量肉芽肿及多核巨细胞,并见灶性坏死,可符合慢性肉芽肿性炎,未见明确恶性特征,请结合临床综合考虑。
分子靶向测序提示真菌——塔宾曲霉
塔宾曲霉是属于散囊菌目发菌科曲霉属的一种真菌,黑曲霉属。2017 年中国科学家从城市垃圾中分离出降解聚氨基甲酸酯的真菌,并鉴定其为塔宾曲霉菌。
肺曲霉菌病
(Pulmonary Aspergillosis)
概 述
由曲霉菌引起的 感染性、进展性、变态反应性 肺部疾病。
我国曲霉菌感染中,烟曲霉感染尤为多见,其次为黄曲霉、黑曲霉、土曲霉等。
感染主要原因:
· 免疫正常人群: 接触大量曲霉菌病史 (拆房、蔬菜大棚、养花等),此类少见
· 免疫抑制人群:
1、基础病 (血液病、肿瘤化疗、营养不良、糖尿病、慢阻肺)
2、长期大量抗生素、激素、免疫抑制剂
3、AIDS
肺内真菌感染途径

辅助检查
真菌培养 及组织病理学检查-金标准
支气管肺泡灌洗液/肺穿刺活检行组织培养及病理检查-痰中找到菌丝尚不能确诊,缺乏特异性
曲霉半乳甘露聚糖测定 (GM 试验)-早期诊断、评估疗效
宏基因组二代测序(mNGS)
临床分型
腐生型肺曲霉病 (曲霉球)
侵袭性肺曲霉病 (IPA)
变应性支气管肺曲霉病 (ABPA)
慢性肺曲霉病
侵袭性肺曲霉菌病
主要见于免疫缺陷患者
临床表现:缺乏特异性,可发热、咳嗽、呼吸困难、咯血及胸痛等
曲霉菌侵犯血管导致血栓形成,伴发急性坏死性、化脓性肺炎,表现为高热、咳嗽、咯血,咳含有曲霉菌的棕色痰栓或脓性痰。
· 血管侵袭性曲霉菌
· 气管侵袭性曲霉菌
01
血管侵袭性曲霉菌
影像学表现——晕征样结节和楔形实变影
早期出现多发密度增高的结节影,周围可见晕征。「晕征」表现为围绕结节周围的略低于结节密度而又高于肺实质密度的环行带状区,其病理基础是肺曲菌破坏肺部小血管,导致肺实质出血性坏死。「晕征」是 IPA 早期最具提示性的特征性 CT 表现,也是活性曲霉菌存在的标志, 见于 40~69% 的早期病例,高峰期为病变的第 5 天(1-30 天)。
「楔形实变影「:表现为以胸膜面为基底节段性实变影,边缘模糊,与栓塞性肺梗死相似,病理基础为出血性肺梗死。
「空气新月征」:坏死空洞内部坏死组织回缩与空洞壁分离而形成。出现于病程后期中性粒细胞回升阶段。

晕征:凝固坏死+病变周围出血

02
气管侵袭性曲霉菌
小叶中心性结节、树芽征 (多发),片状实变区,沿支气管周围分布。

支气管壁增厚,树芽征
早期影像表现:隐匿但关键
肺真菌感染(如侵袭性曲霉病、隐球菌病等)早期诊断困难,真菌侵袭早期,肺泡壁水肿或出血可表现为 GGO,传统认为空洞和空气新月征是肺真菌感染的典型标志,但研究发现,这些征象特异性虽高,却常在中性粒细胞恢复期或感染后 2-3 周才出现,相比之下,磨玻璃影(GGO)、微结节、树芽征(支气管簇集征)、(反)晕征出现更早,却因非特异性被忽视。
本例诊疗随访
入院后予「伏立康唑片(威凡)抗感染治疗,治疗后患者诉咳嗽、咳痰、胸闷、胸痛等症状较前明显好转。
鉴别诊断
· 细菌性感染
· 肺结核
· 肺炎型肺癌
· 肺淋巴瘤
· 肺癌肺内转移
01 鉴别诊断 1——细菌感染
临床病程较短,咳嗽、高热、寒战、血象升高主要为细菌引起的急性炎症,短期治疗后病变吸收
CT 主要表现为:
肺叶或肺段分布实变影,边缘模糊
肺体积无变化,近叶间裂处平直
坏死内见气-液平面
病变强化均匀,炎性充血强化较明显
病例 1-病史摘要
女性,66 岁,咳嗽、咳血丝痰 1 周,胸闷、活动后气促;糖尿病;
WBC 11.6×109/L ↑,C 反应蛋白 23.1↑,肿瘤标志物正常。
PET/CT 图像


痰培养提示
产酸克雷伯菌感染
02 鉴别诊断 2——结核
好发部位: 上叶尖后段及下叶背段
钙化、树芽征多见; 晕征、空气新月征、肺梗死少见
急性/亚急性厚壁空洞,周围卫星灶
多为 肺门侧偏心性空洞,肺门侧引流增厚的支气管,壁可有钙化,壁外缘可有纤维条索增粗长毛刺或受牵拉空洞形态不规则
洞壁不强化或少数仅有纤维包膜轻度强化
病例 2
PET/CT 图像


03 鉴别诊断 3——肺炎型肺癌
影像特征:
外周分布 (起源外围、由外向内蔓延)
实变和磨玻璃阴影
病理性支气管充气征
实变内有密度较低、强化较低区
「假空洞」/「蜂窝」征
周围小结节,树芽征少
间质增厚
胸膜改变:糊墙征
病例 3-病史摘要
男,44 岁,咳嗽、咳白色泡沫样痰
PET/CT 图像




纤支镜病理
肺腺癌(高分化)。
04 鉴别诊断 4—MALT 淋巴瘤
肺原发性淋巴瘤罕见,MALT 淋巴瘤尤为常见。常无症状,与自身免疫性疾病、吸烟相关。
影像表现:
1. 分布:双肺多发、多种形态病灶,右肺中叶受累常见;
2. 较大肿块或实变病灶跨叶分布,内有充气支气管征,可呈囊状扩张;
3. 增强 强化明显,均匀,病变内血管显示清晰;
4. 大多数病灶 FDG 摄取增高。
病例 4-病史摘要
男 57 岁,咳嗽咳痰 1 月,伴发热,CT 检查考虑支气管扩张合并感染。
PET/CT 图像

PET/CT 表现
双肺多发斑片状实变影,内充气支气管征,部分囊状扩张,FDG 摄取不均匀增高,SUVmax5.1
右下肺病灶穿刺病理
黏膜相关淋巴组织结外边缘区淋巴瘤(MALT 淋巴瘤)
05 鉴别诊断 5—肺癌肺内转移
肺癌伴肺转移,周围出现「晕征」——肿瘤周围浸润及间质反应所致。
病例 5


描述
PET/CT 显像全身多发高代谢病变,左上肺癌伴肺、骨广泛转移。
参考文献:
[1] 东南大学附属中大医院放射科,高舒鸿/卢曈,呼吸系统疾病—肺曲霉病;
[2] 江苏省人民医院放射科,肺曲霉菌病-塔宾曲霉菌;
[3] 丁香园影像时间,梁衍舜,肺真菌感染的早期 CT 诊断;
[4] 鼎湖影像,武汉大学人民医院放射科,肺炎型肺癌 CT 诊断;
[5] 刘云,张曦,张松,肺黏膜相关淋巴组织淋巴瘤 MSCT 表现与病理学基础,中华肺部疾病杂志,2019,12(3):281-284.
作者:成蕾 审核:柳伟坤

好文章,需要你的鼓励
















